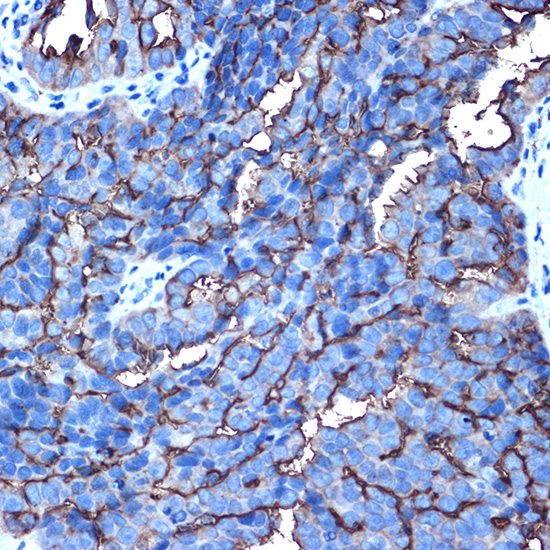
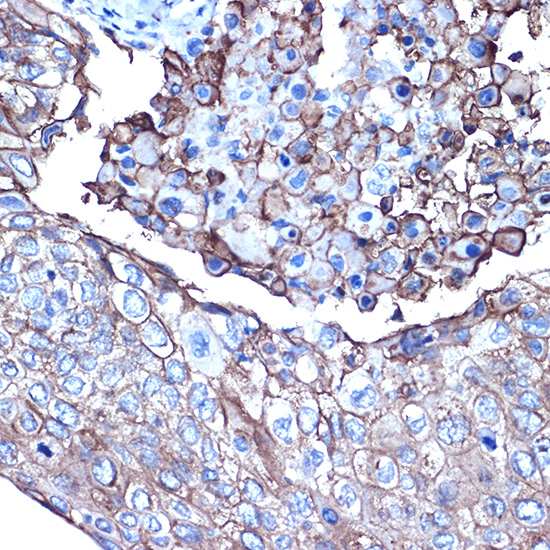

MUC1 Rabbit pAb, Unconjugated
Artikelnummer:
ABB-A0333
- Bilder (10)
| Artikelname: | MUC1 Rabbit pAb, Unconjugated |
| Artikelnummer: | ABB-A0333 |
| Hersteller Artikelnummer: | A0333 |
| Alternativnummer: | ABB-A0333-100UL,ABB-A0333-20UL,ABB-A0333-1000UL,ABB-A0333-500UL |
| Hersteller: | ABclonal |
| Wirt: | Rabbit |
| Kategorie: | Antikörper |
| Applikation: | ELISA, IHC-P, WB |
| Spezies Reaktivität: | Human |
| Immunogen: | Recombinant protein (or fragment).This information is considered to be commercially sensitive. |
| Konjugation: | Unconjugated |
| Alternative Synonym: | EMA, MCD, PEM, PUM, KL-6, MAM6, MCKD, PEMT, CD227, H23AG, MCKD1, MUC-1, ADMCKD, ADTKD2, Ca15-3, ADMCKD1, CA 15-3, MUC-1/X, MUC1/ZD, MUC-1/SEC, MUC1 |
| This gene encodes a membrane-bound protein that is a member of the mucin family. Mucins are O-glycosylated proteins that play an essential role in forming protective mucous barriers on epithelial surfaces. These proteins also play a role in intracellular signaling. This protein is expressed on the apical surface of epithelial cells that line the mucosal surfaces of many different tissues including lung, breast stomach and pancreas. This protein is proteolytically cleaved into alpha and beta subunits that form a heterodimeric complex. The N-terminal alpha subunit functions in cell-adhesion and the C-terminal beta subunit is involved in cell signaling. Overexpression, aberrant intracellular localization, and changes in glycosylation of this protein have been associated with carcinomas. This gene is known to contain a highly polymorphic variable number tandem repeats (VNTR) domain. Alternate splicing results in multiple transcript variants. |
| Application Verdünnung: | WB,1:500 - 1:1000|IHC-P,1:50 - 1:200|ELISA,Recommended starting concentration is 1 µg/mL. Please optimize the concentration based on your specific assay requirements. |
| Anwendungsbeschreibung: | Cross-Reactivity: Human,Mouse,Rat, ResearchArea: Protein phosphorylation,Cancer,Tumor immunology,Tumor-associated antigens,Invasion and Metastasis,Signal Transduction,ErbB-HER Signaling Pathway,Cell Biology Developmental Biology,Cytoskeleton,Extracellular Matrix,Immunology Inflammation,CDs. |